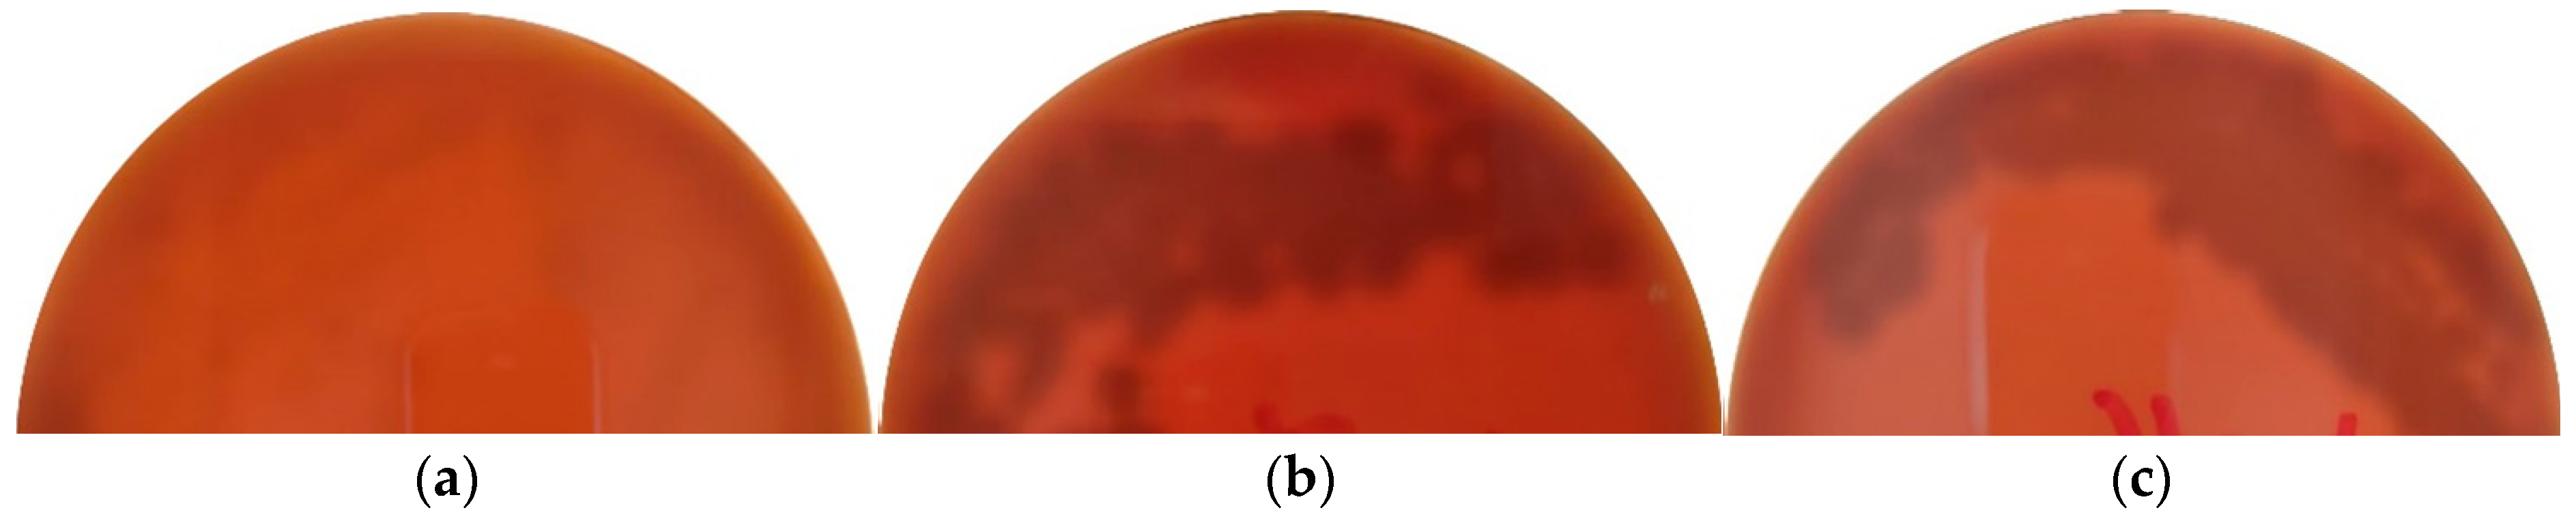

Competitive Exclusion Bacterial Culture Derived from the Gut Microbiome of Nile Tilapia (Oreochromis niloticus) as a Resource to Efficiently Recover Probiotic Strains: Taxonomic, Genomic, and Functional Proof of Concept
Abstract
:1. Introduction
2. Materials and Methods
2.1. Ethical Statement
2.2. Bacteria Selection
2.3. Whole-Genome Sequencing
2.3.1. DNA Extraction, Library Preparation, and Sequencing
2.3.2. Quality Control, Trimming, Assembly of Paired Ends Reads, and Contigs Selection
2.3.3. Whole-Genome Sequencing Identification
2.3.4. Order, Orientation, and Scaffolding of Contigs Assembled
2.3.5. Genome Comparison
2.3.6. Functional Annotation
2.3.7. Data Availability
2.4. Probiotic In Vitro Characterization
2.4.1. Antibacterial Activity against Streptococcus Agalactiae and Aeromonas Hydrophila
2.4.2. Antibiotic Minimal Inhibitory Concentration Determined by Etest Method
2.4.3. Hemolytic Activity
2.4.4. Bile Salts and pH Survival
2.4.5. Hydrophobicity Evaluation
3. Results and Discussion
3.1. Whole-Genome Sequencing Identification
3.2. Pangenome Comparison
3.3. Functional Annotation as an In-Silico Tool for Probiotic Screening in Aquaculture
3.4. Antibacterial Activity
3.5. Antibiotic Minimal Inhibitory Concentration
3.6. Hemolytic Activity
3.7. Bile Salts and pH Survival
3.8. Hydrophobicity Evaluation
4. Conclusions
Supplementary Materials
Author Contributions
Funding
Data Availability Statement
Acknowledgments
Conflicts of Interest
References
- FAO. FAO Yearbook. Fishery and Aquaculture Statistics 2019/FAO Annuaire. Statistiques Des Pêches Et De L’aquaculture 2019/FAO Anuario. Estadísticas De Pesca Y Acuicultura 2019; FAO: Rome, Italy, 2021. [Google Scholar]
- Ullah, A.; Zuberi, A.; Ahmad, M.; Bashir Shah, A.; Younus, N.; Ullah, S.; Khattak, M.N.K. Dietary administration of the commercially available probiotics enhanced the survival, growth, and innate immune responses in Mori (Cirrhinus mrigala) in a natural earthen polyculture system. Fish Shellfish Immunol. 2018, 72, 266–272. [Google Scholar] [CrossRef] [PubMed]
- Giri, S.; Sukumaran, V.; Sen, S.; Jena, P. Effects of dietary supplementation of potential probiotic Bacillus subtilis VSG1 singularly or in combination with Lactobacillus plantarum VSG3 or/and Pseudomonas aeruginosa VSG2 on the growth, immunity and disease resistance of Labeo rohita. Aquac. Nutr. 2014, 20, 163–171. [Google Scholar] [CrossRef]
- Sankar, H.; Philip, B.; Philip, R.; Singh, I. Effect of probiotics on digestive enzyme activities and growth of cichlids, Etroplus suratensis (Pearl spot) and Oreochromis mossambicus (Tilapia). Aquac. Nutr. 2017, 23, 852–864. [Google Scholar] [CrossRef]
- Aly, S.M.; Ahmed, Y.A.-G.; Ghareeb, A.A.-A.; Mohamed, M.F. Studies on Bacillus subtilis and Lactobacillus acidophilus, as potential probiotics, on the immune response and resistance of Tilapia nilotica (Oreochromis niloticus) to challenge infections. Fish Shellfish Immunol. 2008, 25, 128–136. [Google Scholar] [CrossRef]
- Van Doan, H.; Hoseinifar, S.H.; Tapingkae, W.; Tongsiri, S.; Khamtavee, P. Combined administration of low molecular weight sodium alginate boosted immunomodulatory, disease resistance and growth enhancing effects of Lactobacillus plantarum in Nile tilapia (Oreochromis niloticus). Fish Shellfish Immunol. 2016, 58, 678–685. [Google Scholar] [CrossRef]
- Anuar, N.S.; Omar, N.S.; Noordiyana, M.N.; Sharifah, N.E. Effect of commercial probiotics on the survival and growth performance of goldfish Carassius auratus. AACL Bioflux 2017, 10, 1663–1670. [Google Scholar]
- El-Naby, F.S.A.; Naiel, M.A.; Al-Sagheer, A.A.; Negm, S.S. Dietary chitosan nanoparticles enhance the growth, production performance, and immunity in Oreochromis niloticus. Aquaculture 2019, 501, 82–89. [Google Scholar] [CrossRef]
- Santos, L.; Ramos, F. Antimicrobial resistance in aquaculture: Current knowledge and alternatives to tackle the problem. Int. J. Antimicrob. Agents 2018, 52, 135–143. [Google Scholar] [CrossRef]
- Cabello, F.C.; Godfrey, H.P.; Buschmann, A.H.; Dölz, H.J. Aquaculture as yet another environmental gateway to the development and globalisation of antimicrobial resistance. Lancet Infect. Dis. 2016, 16, e127–e133. [Google Scholar] [CrossRef]
- Hossain, A.; Al Mamun, H.; Nagano, I.; Masunaga, S.; Kitazawa, D.; Matsuda, H. Antibiotics, antibiotic-resistant bacteria, and resistance genes in aquaculture: Risks, current concern, and future thinking. Environ. Sci. Pollut. Res. 2022, 29, 11054–11075. [Google Scholar] [CrossRef]
- Jara, B.; Srain, B.M.; Aranda, M.; Fernández, C.; Pantoja-Gutiérrez, S.; Méjanelle, L. Water-sediment partitioning of flumequine and florfenicol, two antibiotics used in salmon aquaculture in Chile. Mar. Pollut. Bull. 2022, 177, 113480. [Google Scholar] [CrossRef] [PubMed]
- Hemamalini, N.; Shanmugam, S.A.; Kathirvelpandian, A.; Deepak, A.; Kaliyamurthi, V.; Suresh, E. A critical review on the antimicrobial resistance, antibiotic residue and metagenomics-assisted antimicrobial resistance gene detection in freshwater aquaculture environment. Aquac. Res. 2021, 53, 344–366. [Google Scholar] [CrossRef]
- Assefa, A.; Abunna, F. Maintenance of Fish Health in Aquaculture: Review of Epidemiological Approaches for Prevention and Control of Infectious Disease of Fish. Vet. Med. Int. 2018, 2018, 5432497. [Google Scholar] [CrossRef] [PubMed]
- De Souza, D.M.; Suita, S.M.; Leite, F.P.L.; Romano, L.A.; Wasielesky, W.; Ballester, E.L.C. The use of probiotics during the nursery rearing of the pink shrimp Farfantepenaeus brasiliensis (Latreille, 1817) in a zero exchange system. Aquac. Res. 2012, 43, 1828–1837. [Google Scholar] [CrossRef]
- Jamal, M.T.; Abdulrahman, I.A.; Al Harbi, M.; Chithambaran, S. Probiotics as alternative control measures in shrimp aquaculture: A review. J. Appl. Biol. Biotechnol. 2019, 7, 69–77. [Google Scholar] [CrossRef] [Green Version]
- Lauzon, H.L.; Dimitroglou, A.; Merrifield, D.L.; Ringø, E.; Davies, S.J. Probiotics and prebiotics: Concepts, definitions and history. In Aquaculture Nutrition: Gut Health, Probiotics and Prebiotics; Merrifield, D.L., Ringø, E., Eds.; John Wiley & Sons: Chennai, India, 2014; pp. 169–184. [Google Scholar]
- Kanwal, Z.; Tayyeb, A. Role of dietary probiotic Ecotec in growth enhancement, thyroid tuning, hematomorphology and resistance to pathogenic challenge in Labeo rohita juveniles. J. Appl. Anim. Res. 2019, 47, 394–402. [Google Scholar] [CrossRef] [Green Version]
- Melo-Bolívar, J.F.; Pardo, R.Y.R.; Hume, M.E.; Díaz, L.M.V. Multistrain probiotics use in main commercially cultured freshwater fish: A systematic review of evidence. Rev. Aquac. 2021, 13, 1758–1780. [Google Scholar] [CrossRef]
- Melo-Bolívar, J.F.; Ruiz-Pardo, R.Y.; Hume, M.E.; Sidjabat, H.E.; Villamil-Diaz, L.M. Probiotics for cultured freshwater fish. Microbiol. Aust. 2020, 41, 105. [Google Scholar] [CrossRef]
- Ringø, E. Probiotics in shellfish aquaculture. Aquac. Fish. 2020, 5, 1–27. [Google Scholar] [CrossRef]
- Mingmongkolchai, S.; Panbangred, W. Bacillusprobiotics: An alternative to antibiotics for livestock production. J. Appl. Microbiol. 2018, 124, 1334–1346. [Google Scholar] [CrossRef]
- Beaz-Hidalgo, R.; Agüeria, D.; Latif-Eugenín, F.; Yeannes, M.I.; Figueras, M.J. Molecular characterization of Shewanella and Aeromonas isolates associated with spoilage of Common carp (Cyprinus carpio). FEMS Microbiol. Lett. 2015, 362, 1–8. [Google Scholar] [CrossRef] [PubMed] [Green Version]
- Ventura, M.; Turroni, F.; van Sinderen, D. Probiogenomics as a tool to obtain genetic insights into adaptation of probiotic bacteria to the human gut. Bioengineered 2012, 3, 73–79. [Google Scholar] [CrossRef] [PubMed] [Green Version]
- Melo-Bolívar, J.F.; Pardo, R.Y.R.; Hume, M.E.; Nisbet, D.J.; Rodríguez-Villamizar, F.; Alzate, J.F.; Junca, H.; Díaz, L.M.V. Establishment and characterization of a competitive exclusion bacterial culture derived from Nile tilapia (Oreochromis niloticus) gut microbiomes showing antibacterial activity against pathogenic Streptococcus agalactiae. PLoS ONE 2019, 14, e0215375. [Google Scholar] [CrossRef] [PubMed]
- Seemann, T. Shovill—Assemble Bacterial Isolate Genomes from Illumina Paired-End Reads. Available online: https://github.com/tseemann/shovill (accessed on 2 January 2022).
- Richter, M.; Rossello-Mora, R.; Oliver Glockner, F.; Peplies, J. JSpeciesWS: A web server for prokaryotic species circumscription based on pairwise genome comparison. Bioinformatics 2016, 32, 929–931. [Google Scholar] [CrossRef] [PubMed]
- Meier-Kolthoff, J.P.; Göker, M. TYGS is an automated high-throughput platform for state-of-the-art genome-based taxonomy. Nat. Commun. 2019, 10, 2182. [Google Scholar] [CrossRef]
- Luo, J.; Wei, Y.; Lyu, M.; Wu, Z.; Liu, X.; Luo, H.; Yan, C. A comprehensive review of scaffolding methods in genome assembly. Brief. Bioinform. 2021, 22, bbab033. [Google Scholar] [CrossRef]
- Bosi, E.; Donati, B.; Galardini, M.; Brunetti, S.; Sagot, M.-F.; Lio, P.; Crescenzi, P.; Fani, R.; Fondi, M. MeDuSa: A multi-draft based scaffolder. Bioinformatics 2015, 31, 2443–2451. [Google Scholar] [CrossRef] [Green Version]
- Meier-Kolthoff, J.P.; Carbasse, J.S.; Peinado-Olarte, R.L.; Göker, M. TYGS and LPSN: A database tandem for fast and reliable genome-based classification and nomenclature of prokaryotes. Nucleic Acids Res. 2021, 50, D801–D807. [Google Scholar] [CrossRef]
- NCBI. RefSeq: NCBI Reference Sequence Database. Available online: https://www.ncbi.nlm.nih.gov/refseq/ (accessed on 9 January 2022).
- Seemann, T. Prokka: Rapid prokaryotic genome annotation. Bioinformatics 2014, 30, 2068–2069. [Google Scholar] [CrossRef]
- Page, A.J.; Cummins, C.A.; Hunt, M.; Wong, V.K.; Reuter, S.; Holden, M.T.G.; Fookes, M.; Falush, D.; Keane, J.A.; Parkhill, J. Roary: Rapid large-scale prokaryote pan genome analysis. Bioinformatics 2015, 31, 3691–3693. [Google Scholar] [CrossRef]
- UniProt, C. UniProt. Available online: https://www.uniprot.org/ (accessed on 19 January 2022).
- Van Heel, A.J.; De Jong, A.; Song, C.; Viel, J.H.; Kok, J.; Kuipers, O.P. BAGEL4: A user-friendly web server to thoroughly mine RiPPs and bacteriocins. Nucleic Acids Res. 2018, 46, W278–W281. [Google Scholar] [CrossRef] [PubMed]
- Brettin, T.; Davis, J.J.; Disz, T.; Edwards, R.A.; Gerdes, S.; Olsen, G.J.; Olson, R.; Overbeek, R.; Parrello, B.; Pusch, G.D.; et al. RASTtk: A modular and extensible implementation of the RAST algorithm for building custom annotation pipelines and annotating batches of genomes. Sci. Rep. 2015, 5, 8365. [Google Scholar] [CrossRef] [PubMed] [Green Version]
- Aziz, R.K.; Devoid, S.; Disz, T.; Edwards, R.A.; Henry, C.S.; Olsen, G.J.; Olson, R.; Overbeek, R.; Parrello, B.; Pusch, G.D.; et al. SEED Servers: High-Performance Access to the SEED Genomes, Annotations, and Metabolic Models. PLoS ONE 2012, 7, e48053. [Google Scholar] [CrossRef] [PubMed] [Green Version]
- NCBI. Basic Local Alignment Search Tool. Available online: https://blast.ncbi.nlm.nih.gov/Blast.cgi (accessed on 2 February 2022).
- Villamil, L.; Tafalla, C.; Figueras, A.; Novoa, B. Evaluation of Immunomodulatory Effects of Lactic Acid Bacteria in Turbot (Scophthalmus maximus). Clin. Diagn. Lab. Immunol. 2002, 9, 1318–1323. [Google Scholar] [CrossRef] [PubMed] [Green Version]
- Flórez, A.B.; Danielsen, M.; Korhonen, J.; Zycka, J.; von Wright, A.; Bardowski, J.; Mayo, B. Antibiotic survey of Lactococcus lactis strains to six antibiotics by Etest, and establishment of new susceptibility-resistance cut-off values. J. Dairy Res. 2007, 74, 262–268. [Google Scholar] [CrossRef]
- EFSA Panel on Additives and Products or Substances used in Animal Feed (FEEDAP). Guidance on the assessment of bacterial susceptibility to antimicrobials of human and veterinary importance. EFSA J. 2012, 10, 2740. [Google Scholar] [CrossRef]
- Buxton, R. Blood agar plates and hemolysis protocols. Am. Soc. Microbiol. 2005, 11, 1–9. [Google Scholar]
- Makled, S.O.; Hamdan, A.M.; El-Sayed, A.M. Effects of dietary supplementation of a marine thermotolerant bacterium, Bacillus paralicheniformis SO-1, on growth performance and immune responses of Nile tilapia, Oreochromis niloticus. Aquac. Nutr. 2019, 25, 817–827. [Google Scholar] [CrossRef]
- Muthukumar, P.; Kandeepan, C. Isolation, identification and characterization of probiotic organisms from intestine of fresh water fishes. Int. J. Curr. Microbiol. Appl. Sci. 2015, 4, 607–616. [Google Scholar]
- Aragón-Rojas, S.; Ruiz-Pardo, R.Y.; Hernández-Sánchez, H.; Quintanilla-Carvajal, M.X. Optimization of the production and stress resistance of the probioticLactobacillus fermentumK73 in a submerged bioreactor using a whey-based culture medium. CyTA—J. Food 2018, 16, 1064–1070. [Google Scholar] [CrossRef] [Green Version]
- Darilmaz, D.; Beyatli, Y.; Yuksekdag, Z. Aggregation and Hydrophobicity Properties of 6 Dairy Propionibacteria Strains Isolated from Homemade Turkish Cheeses. J. Food Sci. 2012, 77, M20–M24. [Google Scholar] [CrossRef] [PubMed]
- Yoon, S.H.; Ha, S.M.; Lim, J.; Kwon, S.; Chun, J. A large-scale evaluation of algorithms to calculate average nucleotide identity. Antonie Van Leeuwenhoek 2017, 110, 1281–1286. [Google Scholar] [CrossRef] [PubMed]
- Arahal, D.R. Whole-genome analyses: Average nucleotide identity. In Methods in Microbiology; Elsevier: Amsterdam, The Netherlands, 2014; Volume 41, pp. 103–122. [Google Scholar]
- Xia, Y.; Lu, M.; Chen, G.; Cao, J.; Gao, F.; Wang, M.; Liu, Z.; Zhang, D.; Zhu, H.; Yi, M. Effects of dietary Lactobacillus rhamnosus JCM1136 and Lactococcus lactis subsp. lactis JCM5805 on the growth, intestinal microbiota, morphology, immune response and disease resistance of juvenile Nile tilapia, Oreochromis niloticus. Fish Shellfish Immunol. 2018, 76, 368–379. [Google Scholar] [CrossRef] [PubMed]
- Abdelfatah, E.N.; Mahboub, H.H.H. Studies on the effect of Lactococcus garvieae of dairy origin on both cheese and Nile tilapia (O. niloticus). Int. J. Vet. Sci. Med. 2018, 6, 201–207. [Google Scholar] [CrossRef] [Green Version]
- Selim, K.M.; Reda, R.M. Improvement of immunity and disease resistance in the Nile tilapia, Oreochromis niloticus, by dietary supplementation with Bacillus amyloliquefaciens. Fish Shellfish Immunol. 2015, 44, 496–503. [Google Scholar] [CrossRef]
- Verschuere, L.; Rombaut, G.; Sorgeloos, P.; Verstraete, W. Probiotic Bacteria as Biological Control Agents in Aquaculture. Microbiol. Mol. Biol. Rev. 2000, 64, 655–671. [Google Scholar] [CrossRef] [PubMed] [Green Version]
- Hoseinifar, S.H.; Sun, Y.-Z.; Wang, A.; Zhou, Z. Probiotics as Means of Diseases Control in Aquaculture, a Review of Current Knowledge and Future Perspectives. Front. Microbiol. 2018, 9, 2429. [Google Scholar] [CrossRef] [PubMed] [Green Version]
- Ibrahem, M.D. Evolution of probiotics in aquatic world: Potential effects, the current status in Egypt and recent prospectives. J. Adv. Res. 2015, 6, 765–791. [Google Scholar] [CrossRef] [Green Version]
- Kaktcham, P.M.; Temgoua, J.-B.; Zambou, F.N.; Diaz-Ruiz, G.; Wacher, C.; Pérez-Chabela, M.D.L. Quantitative analyses of the bacterial microbiota of rearing environment, tilapia and common carp cultured in earthen ponds and inhibitory activity of its lactic acid bacteria on fish spoilage and pathogenic bacteria. World J. Microbiol. Biotechnol. 2017, 33, 32. [Google Scholar] [CrossRef]
- Hindu, S.V.; Chandrasekaran, N.; Mukherjee, A.; Thomas, J. A review on the impact of seaweed polysaccharide on the growth of probiotic bacteria and its application in aquaculture. Aquac. Int. 2018, 27, 227–238. [Google Scholar] [CrossRef]
- Kumar, V.; Roy, S.; Meena, D.K.; Sarkar, U.K. Application of Probiotics in Shrimp Aquaculture: Importance, Mechanisms of Action, and Methods of Administration. Rev. Fish. Sci. Aquac. 2016, 24, 342–368. [Google Scholar] [CrossRef]
- Ringø, E.; Olsen, R.E.; Jensen, I.; Romero, J.; Lauzon, H.L. Application of vaccines and dietary supplements in aquaculture: Possibilities and challenges. Rev. Fish Biol. Fish. 2014, 24, 1005–1032. [Google Scholar] [CrossRef]
- Lazado, C.C.; Caipang, C.M.A. Atlantic cod in the dynamic probiotics research in aquaculture. Aquaculture 2014, 424-425, 53–62. [Google Scholar] [CrossRef]
- Gupta, R.S.; Patel, S.; Saini, N.; Chen, S. Robust demarcation of 17 distinct Bacillus species clades, proposed as novel Bacillaceae genera, by phylogenomics and comparative genomic analyses: Description of Robertmurraya kyonggiensis sp. nov. and proposal for an emended genus Bacillus limiting it only to the members of the Subtilis and Cereus clades of species. Int. J. Syst. Evol. Microbiol. 2020, 70, 5753–5798. [Google Scholar] [CrossRef]
- Chauhan, A.; Singh, R. Probiotics in aquaculture: A promising emerging alternative approach. Symbiosis 2018, 77, 99–113. [Google Scholar] [CrossRef]
- Kumar, A.; Babu, P.P.S.; Roy, S.D.; Razvi, S.S.H.; Charan, R. Synergistic Effects of Two Probiotic Bacteria on Growth, Biochemical, and Immunological Responses of Litopenaeus vannamei (Boone, 1931). Isr. J. Aquac.—Bamidgeh 2014, 66, 20779. [Google Scholar] [CrossRef]
- Parthasarathy, R.; Ravi, D. Probiotic bacteria as growth promoter and biocontrol agent against Aeromonas hydrophila in Catla catla (Hamilton, 1822). Indian J. Fish 2011, 58, 87–93. [Google Scholar]
- Newaj-Fyzul, A.; Al-Harbi, A.; Austin, B. Review: Developments in the use of probiotics for disease control in aquaculture. Aquaculture 2014, 431, 1–11. [Google Scholar] [CrossRef]
- Mamun, M.A.A.; Nasren, S.; Rathore, S.S.; Sidiq, M.J.; Dharmakar, P.; Anjusha, K.V. Assessment of Probiotic in Aquaculture: Functional Changes and Impact on Fish Gut. Microbiol. Res. J. Int. 2019, 29, 1–10. [Google Scholar] [CrossRef] [Green Version]
- Kuebutornye, F.K.A.; Abarike, E.D.; Lu, Y. A review on the application of Bacillus as probiotics in aquaculture. Fish Shellfish Immunol. 2019, 87, 820–828. [Google Scholar] [CrossRef]
- Soltani, M.; Ghosh, K.; Hoseinifar, S.H.; Kumar, V.; Lymbery, A.J.; Roy, S.; Ringø, E. Genus bacillus, promising probiotics in aquaculture: Aquatic animal origin, bio-active components, bioremediation and efficacy in fish and shellfish. Rev. Fish. Sci. Aquac. 2019, 27, 331–379. [Google Scholar] [CrossRef] [Green Version]
- Ninawe, A.; Selvin, J. Probiotics in shrimp aquaculture: Avenues and challenges. Crit. Rev. Microbiol. 2009, 35, 43–66. [Google Scholar] [CrossRef] [PubMed]
- De, B.C.; Meena, D.K.; Behera, B.K.; Das, P.; Das Mohapatra, P.K.; Sharma, A.P. Probiotics in fish and shellfish culture: Immunomodulatory and ecophysiological responses. Fish Physiol. Biochem. 2014, 40, 921–971. [Google Scholar] [CrossRef]
- Hong, H.A.; Duc, L.H.; Cutting, S.M. The use of bacterial spore formers as probiotics. FEMS Microbiol. Rev. 2005, 29, 813–835. [Google Scholar] [CrossRef] [Green Version]
- Tepaamorndech, S.; Chantarasakha, K.; Kingcha, Y.; Chaiyapechara, S.; Phromson, M.; Sriariyanun, M.; Kirschke, C.P.; Huang, L.; Visessanguan, W. Effects of Bacillus aryabhattai TBRC8450 on vibriosis resistance and immune enhancement in Pacific white shrimp, Litopenaeus vannamei. Fish Shellfish Immunol. 2019, 86, 4–13. [Google Scholar] [CrossRef]
- Nguyen, T.L.; Kim, D.-H. Genome-Wide Comparison Reveals a Probiotic Strain Lactococcus Lactis WFLU12 Isolated from the Gastrointestinal Tract of Olive Flounder (Paralichthys Olivaceus) Harboring Genes Supporting Probiotic Action. Mar. Drugs 2018, 16, 140. [Google Scholar] [CrossRef] [Green Version]
- Drillet, G.; Frouël, S.; Sichlau, M.H.; Jepsen, P.M.; Højgaard, J.K.; Joarder, A.K.; Hansen, B.W. Status and recommendations on marine copepod cultivation for use as live feed. Aquaculture 2011, 315, 155–166. [Google Scholar] [CrossRef]
- Xie, S.; Zhou, W.; Tian, L.; Niu, J.; Liu, Y. Effect of N-acetyl cysteine and glycine supplementation on growth performance, glutathione synthesis, anti-oxidative and immune ability of Nile tilapia, Oreochromis niloticus. Fish Shellfish Immunol. 2016, 55, 233–241. [Google Scholar] [CrossRef]
- Haygood, A.M.; Jha, R. Strategies to modulate the intestinal microbiota of Tilapia (Oreochromis sp.) in aquaculture: A review. Rev. Aquac. 2018, 10, 320–333. [Google Scholar] [CrossRef]
- Newsome, S.D.; Fogel, M.L.; Kelly, L.; del Rio, C.M. Contributions of direct incorporation from diet and microbial amino acids to protein synthesis in Nile tilapia. Funct. Ecol. 2011, 25, 1051–1062. [Google Scholar] [CrossRef]
- Huynh, T.-G.; Shiu, Y.-L.; Nguyen, T.-P.; Truong, Q.-P.; Chen, J.-C.; Liu, C.-H. Current applications, selection, and possible mechanisms of actions of synbiotics in improving the growth and health status in aquaculture: A review. Fish Shellfish Immunol. 2017, 64, 367–382. [Google Scholar] [CrossRef] [PubMed]
- Shokryazdan, P.; Sieo, C.C.; Kalavathy, R.; Liang, J.B.; Alitheen, N.B.; Jahromi, M.F.; Ho, Y.W. Probiotic Potential of Lactobacillus Strains with Antimicrobial Activity against Some Human Pathogenic Strains. BioMed Res. Int. 2014, 2014, 927268. [Google Scholar] [CrossRef] [PubMed] [Green Version]
- Sánchez, B.; Bressollier, P.; Urdaci, M.C. Exported proteins in probiotic bacteria: Adhesion to intestinal surfaces, host immunomodulation and molecular cross-talking with the host. FEMS Immunol. Med. Microbiol. 2008, 54, 297–308. [Google Scholar] [CrossRef] [PubMed] [Green Version]
- Whittaker, C.A.; Hynes, R.O. Distribution and Evolution of von Willebrand/Integrin A Domains: Widely Dispersed Domains with Roles in Cell Adhesion and Elsewhere. Mol. Biol. Cell 2002, 13, 3369–3387. [Google Scholar] [CrossRef] [PubMed] [Green Version]
- Haiko, J.; Westerlund-Wikström, B. The Role of the Bacterial Flagellum in Adhesion and Virulence. Biology 2013, 2, 1242–1267. [Google Scholar] [CrossRef] [Green Version]
- Yones, A.-M.M.; Hussein, M.S.; Ali, M.W.; Abdel-Azem, A.-A.M. Effect of dietary Lacto cel-con probiotic on growth performance and hematology indices of fingerlings mono-sex Nile tilapia (Oreochromis niloticus). Egypt. J. Aquat. Biol. Fish. 2019, 23, 227–239. [Google Scholar] [CrossRef] [Green Version]
- Van Doan, H.; Lumsangkul, C.; Hoseinifar, S.H.; Jaturasitha, S.; Tran, H.Q.; Chanbang, Y.; Ringø, E.; Stejskal, V. Influences of spent coffee grounds on skin mucosal and serum immunities, disease resistance, and growth rate of Nile tilapia (Oreochromis niloticus) reared under biofloc system. Fish Shellfish Immunol. 2022, 120, 67–74. [Google Scholar] [CrossRef]
- Van Doan, H.; Lumsangkul, C.; Hoseinifar, S.H.; Harikrishnan, R.; Balasundaram, C.; Jaturasitha, S. Effects of coffee silverskin on growth performance, immune response, and disease resistance of Nile tilapia culture under biofloc system. Aquaculture 2021, 543, 736995. [Google Scholar] [CrossRef]
- Li, E.; Wang, X.; Chen, K.; Xu, C.; Qin, J.G.; Chen, L. Physiological change and nutritional requirement of Pacific white shrimp Litopenaeus vannamei at low salinity. Rev. Aquac. 2017, 9, 57–75. [Google Scholar] [CrossRef]
- Sahraei, F.; Ahari, H.; Kakoolaki, S. Effect of Bacillus subtilis as a probiotic on protein, lipid content, and trypsin and chymotrypsin enzymes in rainbow trout biometry (Oncorhynchus mykiss). Aquac. Int. 2018, 27, 141–153. [Google Scholar] [CrossRef]
- Munglue, P.; Kronghinrach, K.; Rattana, K.; Sangchanjiradet, S.; Dasri, K. Effect of dietary Bacillus pumilus A1_YM_1 on growth, intestinal morphology and some hematological parameters of hybrid catfish (Clarias macrocephalus × Clarias gariepinus). Asia-Pac. J. Sci. Technol. 2019, 24, 1–8. [Google Scholar]
- Kuebutornye, F.K.A.; Abarike, E.D.; Lu, Y.; Hlordzi, V.; Sakyi, M.E.; Afriyie, G.; Wang, Z.; Li, Y.; Xie, C.X. Mechanisms and the role of probiotic Bacillus in mitigating fish pathogens in aquaculture. Fish Physiol. Biochem. 2020, 46, 819–841. [Google Scholar] [CrossRef] [PubMed]
- Kaktcham, P.M.; Kouam, E.M.F.; Tientcheu, M.L.T.; Temgoua, J.-B.; Wacher, C.; Ngoufack, F.Z.; Pérez-Chabela, M.D.L. Nisin-producing Lactococcus lactis subsp. lactis 2MT isolated from freshwater Nile tilapia in Cameroon: Bacteriocin screening, characterization, and optimization in a low-cost medium. LWT 2019, 107, 272–279. [Google Scholar] [CrossRef]
- Cano-Lozano, J.A.; Diaz, L.M.V.; Bolivar, J.F.M.; Hume, M.E.; Pardo, R.Y.R. Probiotics in tilapia (Oreochromis niloticus) culture: Potential probiotic Lactococcus lactis culture conditions. J. Biosci. Bioeng. 2022, 133, 187–194. [Google Scholar] [CrossRef] [PubMed]
- Perry, J.A.; Wright, G.D. The antibiotic resistance “mobilome”: Searching for the link between environment and clinic. Front. Microbiol. 2013, 4, 138. [Google Scholar] [CrossRef] [Green Version]
- Slizovskiy, I.B.; Mukherjee, K.; Dean, C.J.; Boucher, C.; Noyes, N.R. Mobilization of Antibiotic Resistance: Are Current Approaches for Colocalizing Resistomes and Mobilomes Useful? Front. Microbiol. 2020, 11, 1376. [Google Scholar] [CrossRef]
- Pereira, G.D.V.; da Cunha, D.; Mourino, J.P.; Rodiles, A.; Jaramillo-Torres, A.; Merrifield, D. Characterization of microbiota in Arapaima gigas intestine and isolation of potential probiotic bacteria. J. Appl. Microbiol. 2017, 123, 1298–1311. [Google Scholar] [CrossRef]
- Selim, K.M.; El-Sayed, H.M.; El-Hady, M.A.; Reda, R.M. In vitro evaluation of the probiotic candidates isolated from the gut of Clarias gariepinus with special reference to the in vivo assessment of live and heat-inactivated Leuconostoc mesenteroides and Edwardsiella sp. Aquac. Int. 2018, 27, 33–51. [Google Scholar] [CrossRef]
- Chen, W.; Gu, Z. Genomic Analysis of Lactic Acid Bacteria and Their Applications. In Lactic Acid Bacteria in Foodborne Hazards Reduction; Springer: Singapore, 2018; pp. 21–49. [Google Scholar]
- Fallico, V.; McAuliffe, O.; Fitzgerald, G.F.; Ross, R.P. Plasmids of Raw Milk Cheese Isolate Lactococcus lactis subsp. lactis Biovar diacetylactis DPC3901 Suggest a Plant-Based Origin for the Strain. Appl. Environ. Microbiol. 2011, 77, 6451–6462. [Google Scholar] [CrossRef] [Green Version]
- Kumar, H.; Schütz, F.; Bhardwaj, K.; Sharma, R.; Nepovimova, E.; Dhanjal, D.S.; Verma, R.; Kumar, D.; Kuča, K.; Cruz-Martins, N. Recent advances in the concept of paraprobiotics: Nutraceutical/functional properties for promoting children health. Crit. Rev. Food Sci. Nutr. 2021, 1–16. [Google Scholar] [CrossRef]
- Sharma, P.; Tomar, S.K.; Goswami, P.; Sangwan, V.; Singh, R. Antibiotic resistance among commercially available probiotics. Food Res. Int. 2014, 57, 176–195. [Google Scholar] [CrossRef]
- Jose, N.M.; Bunt, C.; Hussain, M.A. Implications of Antibiotic Resistance in Probiotics. Food Rev. Int. 2014, 31, 52–62. [Google Scholar] [CrossRef]
- Rosander, A.; Connolly, E.; Roos, S. Removal of Antibiotic Resistance Gene-Carrying Plasmids from Lactobacillus reuteri ATCC 55730 and Characterization of the Resulting Daughter Strain, L. reuteri DSM 17938. Appl. Environ. Microbiol. 2008, 74, 6032–6040. [Google Scholar] [CrossRef] [PubMed] [Green Version]
- Mladineo, I.; Buselic, I.; Hrabar, J.; Radonić, I.; Vrbatović, A.; Jozić, S.; Trumbić, Ž. Autochthonous Bacterial Isolates Successfully Stimulate In vitro Peripheral Blood Leukocytes of the European Sea Bass (Dicentrarchus labrax). Front. Microbiol. 2016, 7, 1244. [Google Scholar] [CrossRef] [Green Version]
- Ozorio, R.O.; Kopecka-Pilarczyk, J.; Peixoto, M.J.; Lochmann, R.; Santos, R.J.; Santos, G.; Weber, B.; Calheiros, J.; Ferraz-Arruda, L.; Vaz-Pires, P.; et al. Dietary probiotic supplementation in juvenile rainbow trout (Oncorhynchus mykiss) reared under cage culture production: Effects on growth, fish welfare, flesh quality and intestinal microbiota. Aquac. Res. 2016, 47, 2732–2747. [Google Scholar] [CrossRef]
- Sahu, M.K.; Swarnakumar, N.S.; Sivakumar, K.; Thangaradjou, T.; Kannan, L. Probiotics in aquaculture: Importance and future perspectives. Indian J. Microbiol. 2008, 48, 299–308. [Google Scholar] [CrossRef]
- Liu, H.; Wang, S.; Cai, Y.; Guo, X.; Cao, Z.; Zhang, Y.; Liu, S.; Yuan, W.; Zhu, W.; Zheng, Y.; et al. Dietary administration of Bacillus subtilis HAINUP40 enhances growth, digestive enzyme activities, innate immune responses and disease resistance of tilapia, Oreochromis niloticus. Fish Shellfish Immunol. 2017, 60, 326–333. [Google Scholar] [CrossRef]
- Telli, G.S.; Ranzani-Paiva, M.J.T.; de Dias, D.C.; Sussel, F.R.; Ishikawa, C.M.; Tachibana, L. Dietary administration of Bacillus subtilis on hematology and non-specific immunity of Nile tilapia Oreochromis niloticus raised at different stocking densities. Fish Shellfish Immunol. 2014, 39, 305–311. [Google Scholar] [CrossRef]
- Alonso, S.; Castro, M.C.; Berdasco, M.; de la Banda, I.G.; Moreno-Ventas, X.; de Rojas, A.H. Isolation and Partial Characterization of Lactic Acid Bacteria from the Gut Microbiota of Marine Fishes for Potential Application as Probiotics in Aquaculture. Probiotics Antimicrob. Proteins 2019, 11, 569–579. [Google Scholar] [CrossRef]
- Sahoo, T.K.; Jena, P.K.; Nagar, N.; Patel, A.K.; Seshadri, S. In Vitro Evaluation of Probiotic Properties of Lactic Acid Bacteria from the Gut of Labeo rohita and Catla catla. Probiotics Antimicrob. Proteins 2015, 7, 126–136. [Google Scholar] [CrossRef]
- Nguyen, T.L.; Park, C.-I.; Kim, D.-H. Improved growth rate and disease resistance in olive flounder, Paralichthys olivaceus, by probiotic Lactococcus lactis WFLU12 isolated from wild marine fish. Aquaculture 2017, 471, 113–120. [Google Scholar] [CrossRef]
- Schroeter, J.; Klaenhammer, T. Genomics of lactic acid bacteria. FEMS Microbiol. Lett. 2009, 292, 1–6. [Google Scholar] [CrossRef] [PubMed]
- Meidong, R.; Doolgindachbaporn, S.; Jamjan, W.; Sakai, K.; Tashiro, Y.; Okugawa, Y.; Tongpim, S. A novel probiotic Bacillus siamensis B44v isolated from Thai pickled vegetables (Phak-dong) for potential use as a feed supplement in aquaculture. J. Gen. Appl. Microbiol. 2017, 63, 246–253. [Google Scholar] [CrossRef] [Green Version]
- Mohammadi, G.; Hafezieh, M.; Karimi, A.A.; Azra, M.N.; Van Doan, H.; Tapingkae, W.; Abdelrahman, H.A.; Dawood, M.A. The synergistic effects of plant polysaccharide and Pediococcus acidilactici as a synbiotic additive on growth, antioxidant status, immune response, and resistance of Nile tilapia (Oreochromis niloticus) against Aeromonas hydrophila. Fish Shellfish Immunol. 2022, 120, 304–313. [Google Scholar] [CrossRef]
- Ghori, I.; Tabassum, M.; Ahmad, T.; Zuberi, A.; Imran, M. Geotrichum candidum enhanced the Enterococcus faecium impact in improving physiology, and health of Labeo rohita (Hamilton, 1822) by modulating gut microbiome under mimic aquaculture conditions. Turk. J. Fish. Aquat. Sci. 2018, 18, 1255–1267. [Google Scholar] [CrossRef]
- Todorov, S.; Furtado, D.; Saad, S.; Tome, E.; Franco, B. Potential beneficial properties of bacteriocin-producing lactic acid bacteria isolated from smoked salmon. J. Appl. Microbiol. 2011, 110, 971–986. [Google Scholar] [CrossRef] [PubMed] [Green Version]
- Adnan, M.; Patel, M.; Hadi, S. Functional and health promoting inherent attributes of Enterococcus hirae F2 as a novel probiotic isolated from the digestive tract of the freshwater fish Catla catla. PeerJ 2017, 5, e3085. [Google Scholar] [CrossRef] [PubMed] [Green Version]
- Tang, S.; Liu, S.; Zhang, J.; Zhou, L.; Wang, X.; Zhao, Q.; Weng, W.; Qin, J.G.; Chen, L.; Li, E. Relief of hypersaline stress in Nile tilapia Oreochromis niloticus by dietary supplementation of a host-derived Bacillus subtilis strain. Aquaculture 2020, 528, 735542. [Google Scholar] [CrossRef]
- Kavitha, M.; Raja, M.; Perumal, P. Evaluation of probiotic potential of Bacillus spp. isolated from the digestive tract of freshwater fish Labeo calbasu (Hamilton, 1822). Aquac. Rep. 2018, 11, 59–69. [Google Scholar] [CrossRef]

| Bacteria | ANIb | ANIm | Tetra |
|---|---|---|---|
| A12 | Lactococcus lactis subsp. lactis ATCC 19435 [T] (97.1%) | Lactococcus lactis subsp. lactis JCM 5805 = NBRC 100933 [T] (98.1%) | Lactococcus lactis subsp. lactis ATCC 19435 [T] (0.998) |
| M4 | Priestia megaterium Riq5 (96.46%) | Priestia megaterium Riq5 (97.39%) | Priestia aryabhattai LK25 (0.999) |
| M10 | Priestia aryabhattai LK25 (98.96%) | Priestia aryabhattai LK25 (99.31%) | Priestia aryabhattai LK25 (0.999) |
| Bacteria | Gen | NCBI Reference | Scaffold | Position | Size (nt) | Size (aa) | Strand |
|---|---|---|---|---|---|---|---|
| A12 | Lactococcin family bacteriocin | WP_153242284.1 | 1 | 2090503-2090715 | 213 | 71 | + |
| M4 | Paeninodin family lasso peptide | WP_014461234.1 | 1 | 1055241-1055366 | 126 | 42 | + |
| M10 | Bacteriocin uviB | WP_097813194.1 | 29 | 13487-13263 | 225 | 75 | − |
| A12 | Cut-Off Value * | M4 | Cut-Off Value ** | M10 | Cut-Off Value ** | |
|---|---|---|---|---|---|---|
| Streptomycin | 24–32 (S) | 32 | 0.25 (S) | 8 | 0.5–0.75 (S) | 8 |
| Ciprofloxacin | 0.75 | not reported | 0.47 | not reported | 0.64 | not reported |
| Kanamycin | 8 (S) | 64 | 0.94 (S) | 8 | 0.125 (S) | 8 |
| Tetracycline | ≥256 (R) | 4 | 0.25 (S) | 8 | 0.5 (S) | 8 |
| Ampicilin | 0.094–0.125 (S) | 2 | 0.25–0.50 | n.r | 0.125–0.19 | n.r |
| Vancomycin | 0.50 (S) | 4 | 0.19 (S) | 4 | 0.75–1.5 (S) | 4 |
| Clindamycin | 0.25–0.38 (S) | 1 | 32 (R) | 4 | 48 (R) | 4 |
| Gentamicin | 1.5–2.0 (S) | 32 | 0.016 (S) | 4 | 0.023 (S) | 4 |
| Cloramphenicol | 3.00 (S) | 8 | 3 (S) | 8 | 2 (S) | 8 |
| Bacteria | Chloroform (%) | Ethyl Acetate (%) |
|---|---|---|
| L. lactis A12 | 92 ± 0.02 | 79 ± 0.01 |
| Priestia sp. M10 | 83 ± 0.04 | 23 ± 0.19 |
| P. megaterium M4 | 29 ± 0.07 | 0 ± 0.00 |
Publisher’s Note: MDPI stays neutral with regard to jurisdictional claims in published maps and institutional affiliations. |
© 2022 by the authors. Licensee MDPI, Basel, Switzerland. This article is an open access article distributed under the terms and conditions of the Creative Commons Attribution (CC BY) license (https://creativecommons.org/licenses/by/4.0/).
Share and Cite
Melo-Bolívar, J.F.; Ruiz Pardo, R.Y.; Junca, H.; Sidjabat, H.E.; Cano-Lozano, J.A.; Villamil Díaz, L.M. Competitive Exclusion Bacterial Culture Derived from the Gut Microbiome of Nile Tilapia (Oreochromis niloticus) as a Resource to Efficiently Recover Probiotic Strains: Taxonomic, Genomic, and Functional Proof of Concept. Microorganisms 2022, 10, 1376. https://doi.org/10.3390/microorganisms10071376
Melo-Bolívar JF, Ruiz Pardo RY, Junca H, Sidjabat HE, Cano-Lozano JA, Villamil Díaz LM. Competitive Exclusion Bacterial Culture Derived from the Gut Microbiome of Nile Tilapia (Oreochromis niloticus) as a Resource to Efficiently Recover Probiotic Strains: Taxonomic, Genomic, and Functional Proof of Concept. Microorganisms. 2022; 10(7):1376. https://doi.org/10.3390/microorganisms10071376
Chicago/Turabian StyleMelo-Bolívar, Javier Fernando, Ruth Yolanda Ruiz Pardo, Howard Junca, Hanna Evelina Sidjabat, Juan Andrés Cano-Lozano, and Luisa Marcela Villamil Díaz. 2022. "Competitive Exclusion Bacterial Culture Derived from the Gut Microbiome of Nile Tilapia (Oreochromis niloticus) as a Resource to Efficiently Recover Probiotic Strains: Taxonomic, Genomic, and Functional Proof of Concept" Microorganisms 10, no. 7: 1376. https://doi.org/10.3390/microorganisms10071376
APA StyleMelo-Bolívar, J. F., Ruiz Pardo, R. Y., Junca, H., Sidjabat, H. E., Cano-Lozano, J. A., & Villamil Díaz, L. M. (2022). Competitive Exclusion Bacterial Culture Derived from the Gut Microbiome of Nile Tilapia (Oreochromis niloticus) as a Resource to Efficiently Recover Probiotic Strains: Taxonomic, Genomic, and Functional Proof of Concept. Microorganisms, 10(7), 1376. https://doi.org/10.3390/microorganisms10071376

